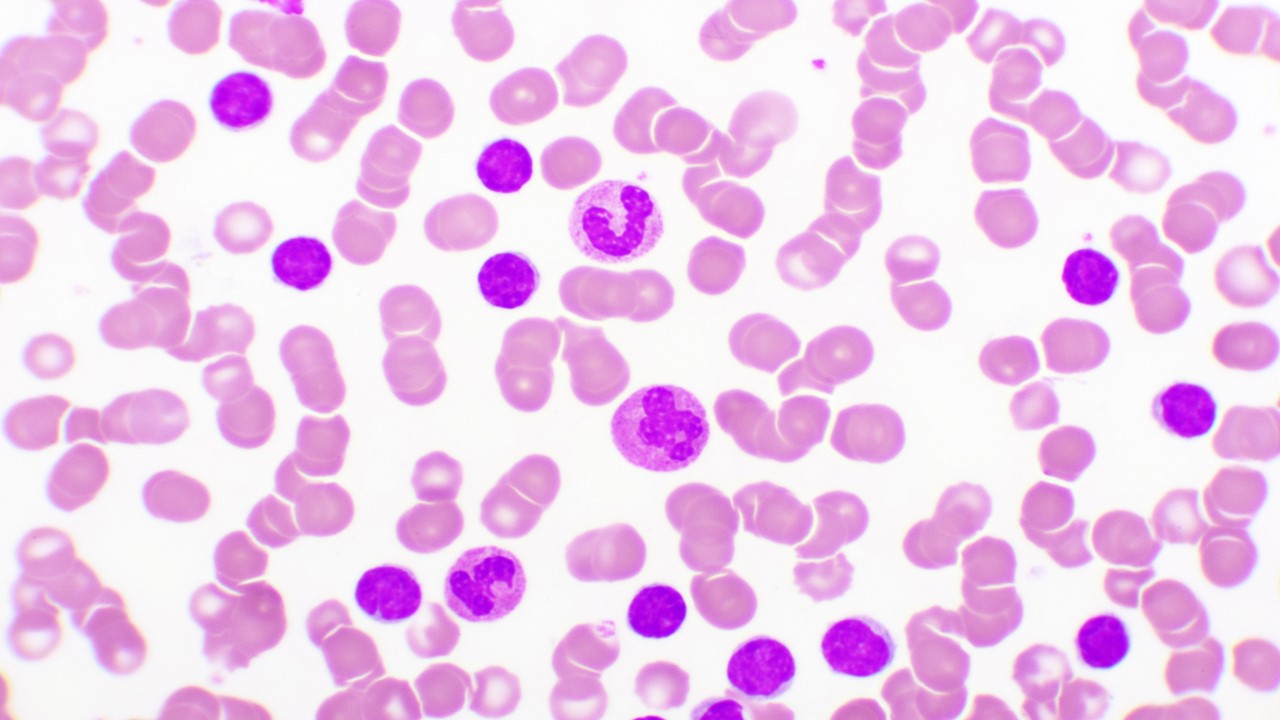
LLA de células-B R/R: la FDA aprueba obecabtagene autoleucel, estudio FELIX

El 8 de noviembre, la FDA aprobó a obecabtagene autoleucel, una terapia celular innovadora dirigida a CD19, para adultos con leucemia linfoblástica aguda (LLA) de precursores de células B en recaída o refractaria. Este tratamiento, que utiliza células T autólogas modificadas genéticamente, ofrece una nueva opción terapéutica para aquellos pacientes que no responden a los tratamientos convencionales.
Esta aprobación se basó en los resultados del estudio FELIX, un estudio multicéntrico y abierto que incluyó a 65 adultos con LLA CD19-positiva en recaída o refractaria. Los pacientes incluidos debían cumplir con ciertos criterios, como haber tenido recaída tras una remisión de 12 meses o menos, o haber experimentado recaída o refractariedad después de al menos dos tratamientos sistémicos previos. Otros pacientes tenían enfermedad que había recaído o sido refractaria tres meses después de un trasplante de células madre alogénicas.
Los resultados mostraron que el 42% de los pacientes (IC del 95%: 29%, 54%) lograron remisión completa (RC) dentro de los tres meses posteriores a la infusión de obecabtagene autoleucel, con una duración media de la RC de 14.1 meses (IC del 95%: 6.1 meses, no alcanzada).
Los efectos secundarios más comunes fueron: infecciones de patógenos no especificados, dolor musculoesquelético, infecciones virales, fiebre, náuseas, infecciones bacterianas, diarrea, neutropenia febril, hipotensión, fatiga, dolor de cabeza, encefalopatía y hemorragia.
El medicamento se administra en dos infusiones de 410 x 10^6 células viables. Se advierte sobre efectos adversos graves como el síndrome de liberación de citoquinas (75%) y toxicidad neurológica (64%).
Fuente consultada:
FDA approves obecabtagene autoleucel for adults with relapsed or refractory B-cell precursor acute lymphoblastic leukemia. https://www.fda.gov/drugs/resources-information-approved-drugs/fda-approves-obecabtagene-autoleucel-adults-relapsed-or-refractory-b-cell-precursor-acute?utm_medium=email&utm_source=govdelivery. Comunicado de prensa. Acceso el 08 de noviembre de 2024.
Noticia redactada por Karem Vázquez
Para aclaraciones y comentarios contactar al correo [email protected]
¿No tienes una cuenta? Regístrate